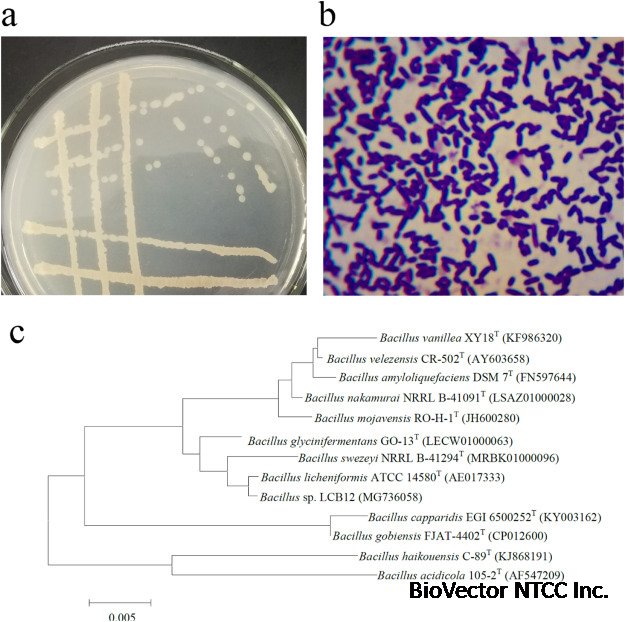
High-expression keratinase by Bacillus subtilis SCK6 for enzymatic  dehairing of goatskins - ScienceDirect

B. subtilis SCK6 NTCC®分泌性蛋白酶表达枯草芽孢杆菌宿主菌株-BioVector NTCC质粒载体菌株细胞蛋白抗体基因保藏中心
- 价 格:¥59850
- 货 号:BioVector®-BSCK6
- 产 地:北京
- BioVector NTCC典型培养物保藏中心
- 联系人:Dr.Xu, Biovector NTCC Inc.
电话:400-800-2947 工作微信:1843439339 (QQ同号)
邮件:Biovector@163.com
手机:18901268599
地址:北京
- 已注册
B. subtilis SCK6 NTCC®分泌性蛋白酶表达枯草芽孢杆菌宿主菌株-BioVector NTCC质粒载体菌株细胞蛋白抗体基因保藏中心
- The genotype of SCK6 is his, nprR2, nprE18, ∆aprA3, ∆eglS102, ∆bglT, bglSRV, lacA::PxylA-comK, erm.
- You can obtain the SCK6 strain from BioVector NTCC Inc. www.biovector.net
- SCK6 is often used to produce secretory enzymes because it's deficient in two major extracellular proteases.
- SCK6 cells can be used to bypass the need for energy starvation in the traditional transformation process. This is because the SCK6 strain has a plasmid that overexpresses comK, the master regulator of competence in B. subtilis.
- A new protocol has been developed for directly transforming B. subtilis using SCK6 cells and multimeric plasmids. This protocol is simple, fast, and highly efficient.
BioVector NTCC质粒载体菌株细胞蛋白抗体基因保藏中心
www.biovector.net
- 公告/新闻




